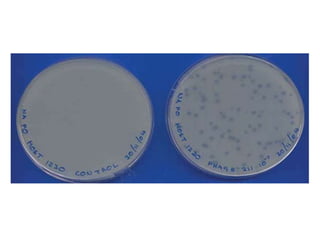

This document provides an introduction to virology, discussing the nature of viruses and their genomes. It explains that viruses need living cells to survive and have either DNA or RNA genomes that are single or double stranded. It describes why viruses are studied, noting they can infect all life and led to discoveries in molecular biology. Some major milestones are discussed, like contributions of bacteriophages to molecular biology and understanding cancer from tumor viruses. Viruses can also be engineered as vector viruses to insert genes into hosts for therapeutic purposes. Common detection techniques like plaque forming and hemagglutination assays are also mentioned.